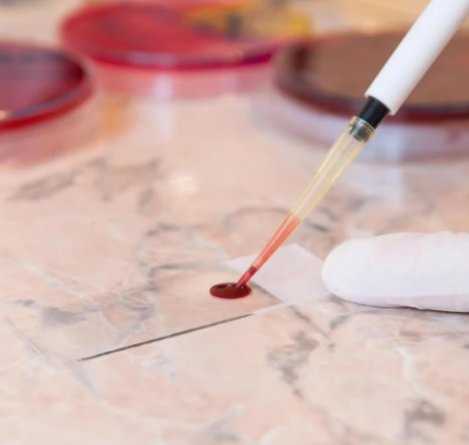

Kjo është 25 vjeçarja nga Gjakova qe u gjet e vdekur në Tetovë

Për katër vite mbi 6 mijë çifte i dhanë fund martesës së tyre!

Tragjedi në Tetovë: Gjendet e vdekur një 25-vjeçare nga Kosova

Raporti i Progresit: Sanksionet hiqen “kur të bartet pushteti lokal në veri”

Mblidhet PS, Rama-deputetëve të Tiranës: Pavarësisht vendimit të Kushtetueses, të jemi gati për zgjedhje

Abdixhiku në Prishtinë: Prishtina flet e para, Përparimi i pari – fitore dhe asgjë më pak

Zgjedhjet në Tiranë dhe Veliaj/ Rama mbledh deputetët e kryeqytetit në PS

Mblidhet PDK-ja: Zgjedhjet e parakohshme, zgjidhja e vetme për tejkalimin e krizës institucionale
Responsive Infinite Carousel Ofertat nga Gorenje Department Store dhe 75mall-
20 qytetet më të pasura në botë

-
Britaniku refuzon intervistën për punë sepse do të intervistohej nga IA

-
Një kalimtar puth presidenten meksikane në qafë dhe përpiqet t’ia prekte gjoksin

-
Bastet që po shkaktojnë mjerimin, si u fiksuan italianët me bixhozin?

-
Si t’i motivoni punonjësit tuaj?

-
“Shmangni shqetësimin e tepërt”/ Parashikimi i yjeve për shenjat e horoskopit

-
Abuzimi seksual, mbrojtja, parandalimi dhe mbështetja për viktimat

-
Fëmijët që punojnë në vend të shkollës: Një realitet i dhimbshëm në Kosovë

-
Të ndërpritet me urgjencë vakumi institucional

-
Ekspozitë me fotografi të viteve 90-ta në Kosovë, nga fotoreporteri kroat Zoran Filipovic

-
Qeveria foli për drejtësi, por qeverisi me moral, opozita kërkoi pushtet, por mrizoj në mungesë të ideve!

-
Pornografia, ndikimi tek adoleshentët dhe të rriturit


Me spinaq e makarona, si e festoi Diddy ditëlindjen në burg?

“Ende ka shpresë?”, Shpati bën të papriturën ndaj Selvijes

Çifti i “Përputhen” gati për celebrim, iu ndodh e papritura

“Takim nate”, Capital T ia fsheh fytyrën Adroles

Angelina Jolie viziton një maternitet dhe një spital në Ukrainë

Ekskluzive/ Çka ndodhi me duetin e bujshëm Dafina-Fero? Përgjigjet Rinor Hykolli

Dafina prishet edhe me Feron, menaxhmenti i saj hedh akuza pas publikimit të këngës
-

Izraeli kthen trupat e 15 palestinezëve në Gaza
-

Nëntori kuq e zi, nga tani me pako turistike për të vizituar “Air Albanian”
-

Dyshohet se bënte thirrje për kalifat, shteti gjerman mbyll një shoqatë myslimane
-

Kosovarja Liridona Muzaqi me biçikletë përshkoi 5000 km nga Gjermania në Kosovë
-

Kush është vizionari Zohran Mamdani – kryebashkiaku i ri i Nju-Jorkut?
-

Demokratët fitojnë në garat kryesore të zgjedhjeve në SHBA
-

Pesë ushtrimet që ju ndihmojnë të vraponi më shpejt
-

Si mund të stërviteni pa shkuar në palestër?
-

7 mijë hapa në ditë mund të ulin rreziqet shëndetësore
-

Ushtrimet fizike në mënyrë të rregullt mund ta mbajnë trupin 30 vite më të ri
-

Dy aksidente të rënda në Veternik, pak metra larg njëri-tjetrit
-

Gjetjet mortore, Haliti: Nëse kemi identifikim pozitiv përmes metodave shkencore të ADN, do t’i njoftojmë familjarët
-

“Liria ka Emër”/ Motoristët që u nisën drejt Hagës arrijnë në Gjermani
-

Audi planifikon tre inovacione të mëdha për vitin 2026
-

Peugeot jep pamjet e para se si do të duket modeli 208-sh i ardhshëm
-

Kia thyen rekordin Guinness, ja për çka bëhet fjalë
-

Zbritje të frikshme të Aprilia! Kush e do motorin, ky është momenti!
-

Makinat luksoze vidheshin “me stil” në Angli dhe dërgoheshin në Dubai, zbulohet skema që përdornin bandat kriminale
-